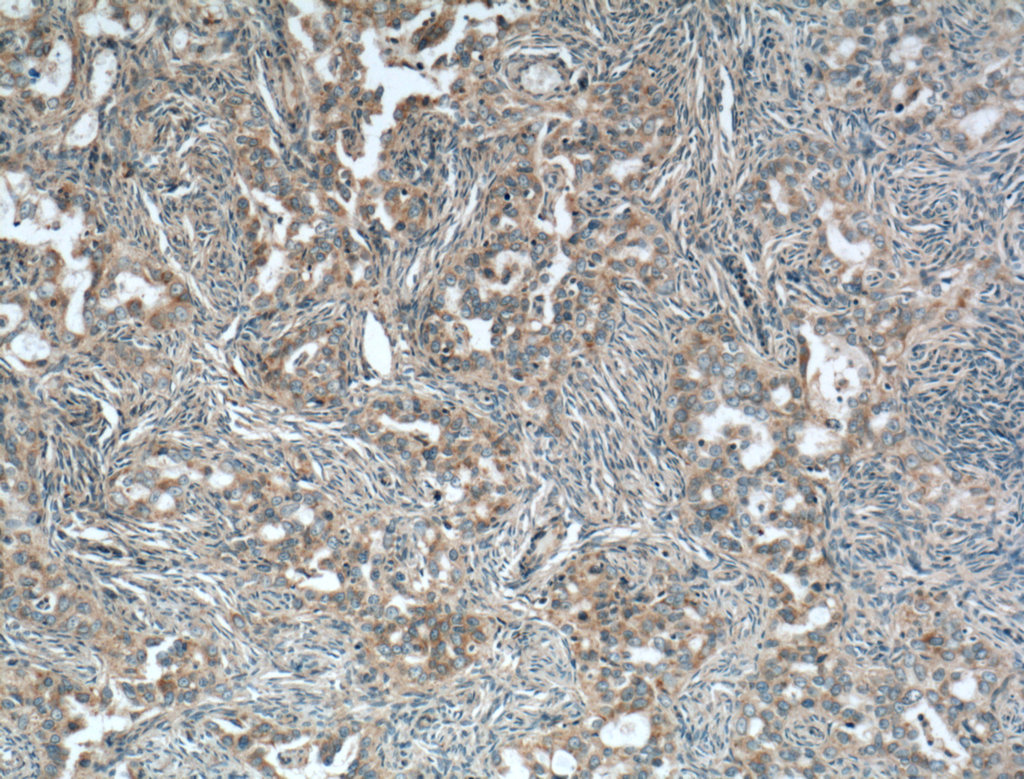

验证数据展示
经过测试的应用
| Positive WB detected in | A549 cells, HeLa cells, Caco-2 cells, MDA-MB-231 cells, Jurkat cells, MOLT-4 cells, K-562 cells, Karpas-299 cells, human skeletal muscle tissue |
| Positive IHC detected in | human ovary tumor tissue, mouse brain tissue Note: suggested antigen retrieval with TE buffer pH 9.0; (*) Alternatively, antigen retrieval may be performed with citrate buffer pH 6.0 |
| Positive IF/ICC detected in | Jurkat cells |
推荐稀释比
| 应用 | 推荐稀释比 |
|---|---|
| Western Blot (WB) | WB : 1:5000-1:50000 |
| Immunohistochemistry (IHC) | IHC : 1:50-1:500 |
| Immunofluorescence (IF)/ICC | IF/ICC : 1:400-1:1600 |
| It is recommended that this reagent should be titrated in each testing system to obtain optimal results. | |
| Sample-dependent, Check data in validation data gallery. | |
发表文章中的应用
| WB | See 4 publications below |
| IF | See 2 publications below |
产品信息
66401-1-Ig targets NDP52 in WB, IHC, IF/ICC, ELISA applications and shows reactivity with human, mouse, rat samples.
| 经测试应用 | WB, IHC, IF/ICC, ELISA Application Description |
| 文献引用应用 | WB, IF |
| 经测试反应性 | human, mouse, rat |
| 文献引用反应性 | human, mouse |
| 免疫原 |
CatNo: Ag2866 Product name: Recombinant human CALCOCO2 protein Source: e coli.-derived, PGEX-4T Tag: GST Domain: 1-283 aa of BC015893 Sequence: MEETIKDPPTSAVLLDHCHFSQVIFNSVEKFYIPGGDVTCHYTFTQHFIPRRKDWIGIFRVGWKTTREYYTFMWVTLPIDLNNKSAKQQEVQFKAYYLPKDDEYYQFCYVDEDGVVRGASIPFQFRPENEEDILVVTTQGEVEEIEQHNKELCKENQELKDSCISLQKQNSDMQAELQKKQEELETLQSINKKLELKVKEQKDYWETELLQLKEQNQKMSSENEKMGIRVDQLQAQLSTQEKEMEKLVQGDQDKTEQLEQLKKENDHLFLSLTEQRKDQKKLE 种属同源性预测 |
| 宿主/亚型 | Mouse / IgG2a |
| 抗体类别 | Monoclonal |
| 产品类型 | Antibody |
| 全称 | calcium binding and coiled-coil domain 2 |
| 别名 | CALCOCO2, 2F2C2, Calcium-binding and coiled-coil domain-containing protein 2, Nuclear domain 10 protein 52, Nuclear dot protein 52 |
| 计算分子量 | 446 aa, 52 kDa |
| 观测分子量 | 52 kDa |
| GenBank蛋白编号 | BC015893 |
| 基因名称 | NDP52 |
| Gene ID (NCBI) | 10241 |
| RRID | AB_2881775 |
| 偶联类型 | Unconjugated |
| 形式 | Liquid |
| 纯化方式 | Protein A purification |
| UNIPROT ID | Q13137 |
| 储存缓冲液 | PBS with 0.02% sodium azide and 50% glycerol, pH 7.3. |
| 储存条件 | Store at -20°C. Stable for one year after shipment. Aliquoting is unnecessary for -20oC storage. |
背景介绍
NDP52, also named as CALCOCO2, is an autophagy receptor. It plays a role in ruffle formation and actin cytoskeleton organization. Mouse/Rat NDP52 has some isoforms with MW 28-40 kDa and 67 kDa. Human NDP52 has some isoforms with MW 43-47 kDa and 52-55 kDa,
实验方案
| Product Specific Protocols | |
|---|---|
| IF protocol for NDP52 antibody 66401-1-Ig | Download protocol |
| IHC protocol for NDP52 antibody 66401-1-Ig | Download protocol |
| WB protocol for NDP52 antibody 66401-1-Ig | Download protocol |
| Standard Protocols | |
|---|---|
| Click here to view our Standard Protocols |
发表文章
| Species | Application | Title |
|---|---|---|
mBio The nonstructural protein 1 of respiratory syncytial virus hijacks host mitophagy as a novel mitophagy receptor to evade the type I IFN response in HEp-2 cells | ||
Immunity The cGAS-STING pathway activates transcription factor TFEB to stimulate lysosome biogenesis and pathogen clearance | ||
Cell Rep Inhibiting UPF1 methylation enhances tumor immunotherapy sensitivity by reducing nonsense-mediated mRNA decay |